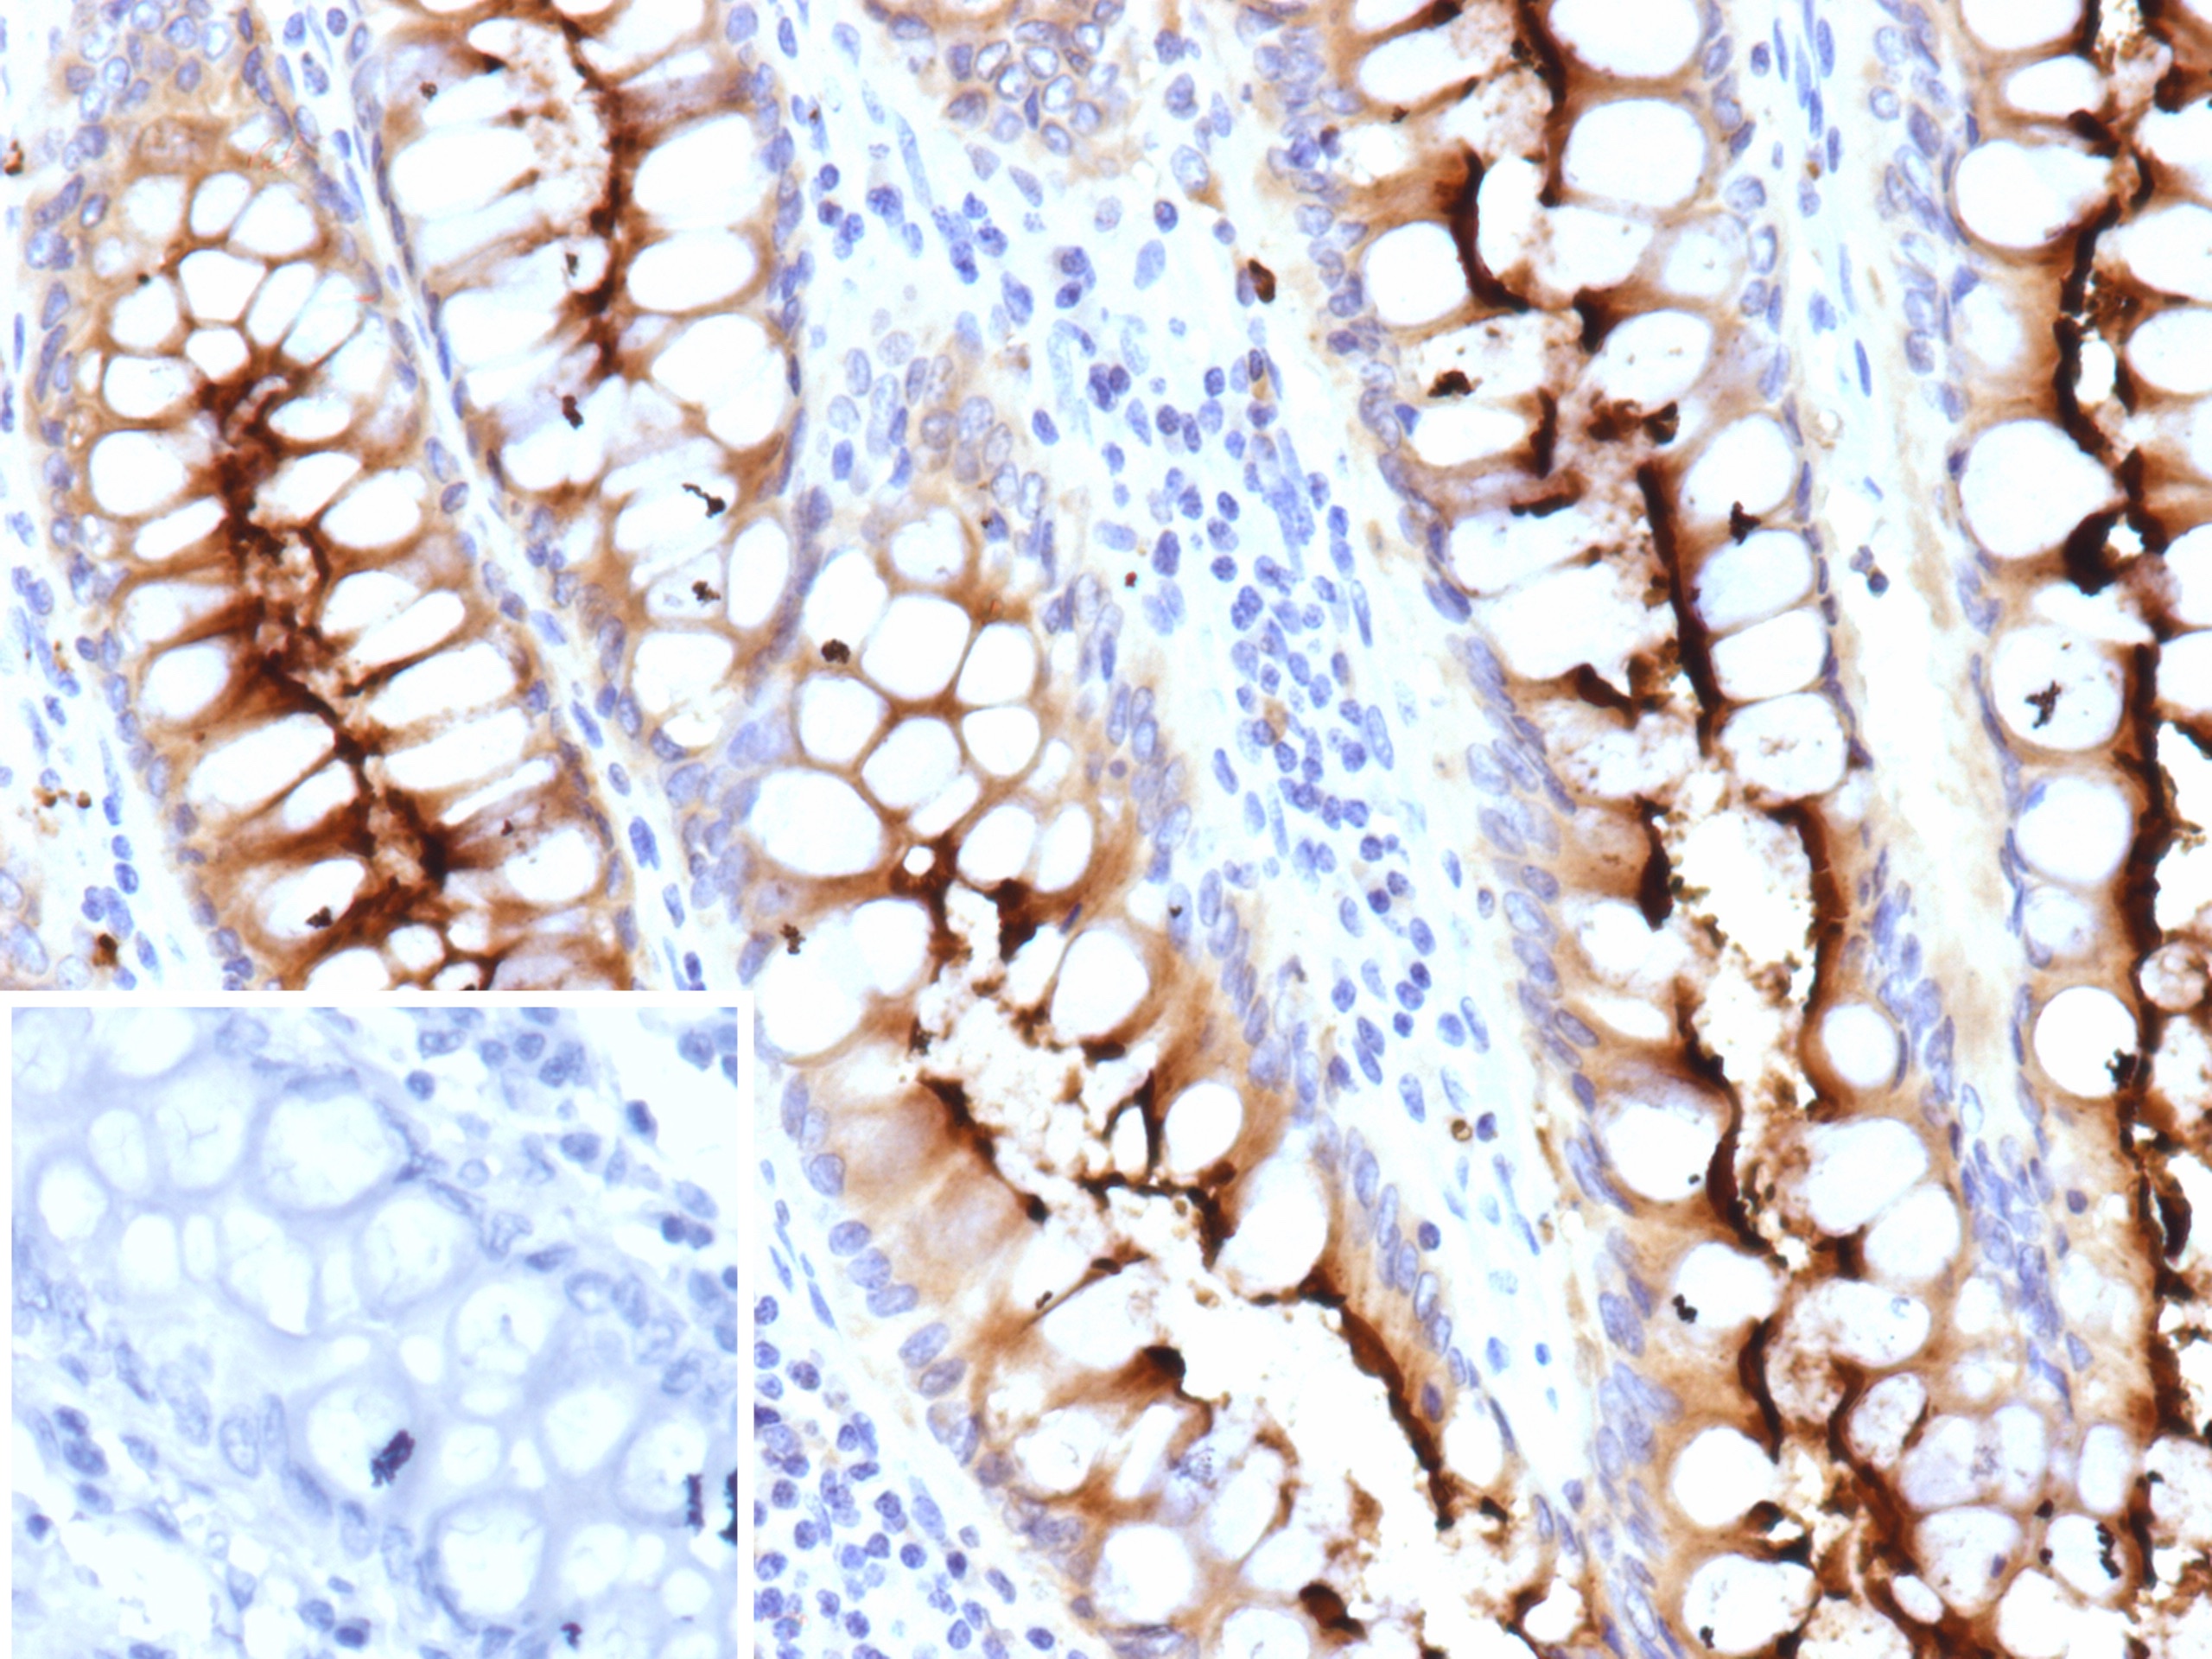

Formalin-fixed, paraffin-embedded human colon carcinoma stained with CEACAM6 / CD66c Recombinant Rabbit Monoclonal Antibody (CEACAM6/10079R). Inset: PBS instead of primary antibody; secondary only negative control.
The CD66 (also designated carcinoembryonic antigen, CEA, biliary glycoprotein I, BGP-1, CEACAM) immunoglobulin superfamily of genes encode cell adhesion proteins, which are expressed at higher levels in tumorous tissues than in normal tissues. CD66 mRNA is strongly expressed in primary colon tumors and, to a lesser extent, in normal colonic tissue. The human CD66 gene family is a diverse set of glycoproteins of epithelial and hematopoietic lineage that comprises 29 genes, which map to chromosome position 19q13.1-q13.2. CD66A, CD66B, CD66C, CD66D, CD66E and CD66F are the best characterized CD66 antigens, and CD66A-D expression upregulates on the surface of granulocytes upon stimulation. Certain CD66 isoforms mediate homotypic and heterotypic intercellular adhesion events independently of cell type.
There are no reviews yet.